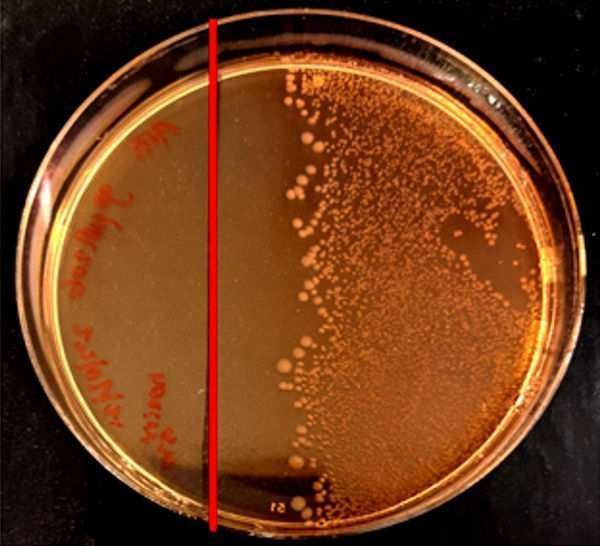

Shah
@drabshah.bsky.social
34 followers
29 following
15 posts
PhD in Natural Product Chemistry, Bioactive compounds from Human microbiota and Plant and their Biological Activities, LCMS and Molecular Networking
Posts
Media
Videos
Starter Packs
Shah
@drabshah.bsky.social
· Aug 7
Shah
@drabshah.bsky.social
· Aug 7

Integrative metabolomics and system pharmacology reveal the antioxidant blueprint of Psoralea corylifolia - Scientific Reports
Scientific Reports - Integrative metabolomics and system pharmacology reveal the antioxidant blueprint of Psoralea corylifolia
www.nature.com
Shah
@drabshah.bsky.social
· Jul 11

Response Surface Methodology Optimization on Ultrasonic‐Assisted Extraction of Chicory (Cichorium intybus L.) and Their UPLC‐ESI‐QTOF‐MS Analysis, Antioxidant and Hepatoprotective Activity
Extraction optimization of antioxidant and hepatoprotective composition from Chicory.
iadns.onlinelibrary.wiley.com
Reposted by Shah
Reposted by Shah
Shah
@drabshah.bsky.social
· May 25
Shah
@drabshah.bsky.social
· May 21
Shah
@drabshah.bsky.social
· May 21
Reposted by Shah
Shah
@drabshah.bsky.social
· May 17
Shah
@drabshah.bsky.social
· May 15
Shah
@drabshah.bsky.social
· May 15

Probiotic significance of Lactobacillus strains: a comprehensive review on health impacts, research gaps, and future prospects
A rising corpus of research has shown the beneficial effects of probiotic Lactobacilli on human health, contributing to the growing popularity of these microorganisms in recent decades. The gastroi...
www.tandfonline.com
Shah
@drabshah.bsky.social
· May 14

Human microbiota peptides: important roles in human health
Covering: 1974 to 2024
Human microbiota consist of a diverse array of microorganisms, such as bacteria, Eukarya, archaea, and viruses, which populate various parts of the human body and live in ...
pubs.rsc.org